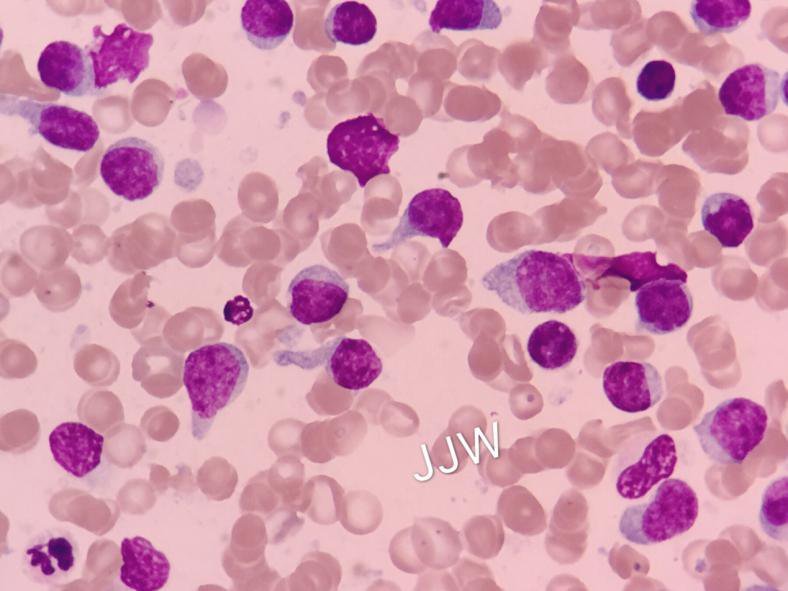
白血病人补硒（白血病补硒人会变瘦吗）-硒宝网

白血病人补硒(白血病补硒人会变瘦吗)
白血病患者血清硒、VEGF和sFas水平相关性研究首都医科大学硕士学位论文白血病患者血清硒、VEGF和sFas水平相关性研究姓名:****学位级别:硕士专业:内科学(血液系病)指导教师:**强20070301首都医科大学学位论文原创性声明本人郑重声明:所呈交的论文是本人在导师的指导下独立进行研究所取得的研究成果。除了文中特别加以标注引用的内容外,本论文不包含任何其他作者签名:互粤复日期:唧年月朔学位论文版权使用授权书本学位论文作者完全了解学校有关保留、使用学位论文的规定,同意学校保留并向国家有关部门或机构送交论文的复印件和电子版,允许论文被查阅本学位论文属于请在以下相应方框内打“”:、保密口,在一年解密后适用本授权书。、不保密彰作者签名:互荡日期:卉年铲日导师签名:剐铴’日期。。一年月谬日、首都医科大学硕士学位论文白血病患者血清硒、和水平相关性研究中文摘要目的硒是人体必需的微量元素之一,具有防癌抗癌作用。体外实验研究表明,硒可以通过诱导肿瘤细胞凋亡,抑制肿瘤血管新生等机制发挥抗癌作用。本研究组的前期研究表明;亚硒酸钠可以诱导白血病细胞系细胞凋亡;提高耐药白血病细胞系/细胞对化疗药物的敏感性,逆转细胞耐药;并能抑制,细胞的表达。
但关于硒诱导凋亡,逆转耐药作用机制的体内研究较少。为了解硒在白血病患者体内是否以同样的机制发挥癌作用,本文选择凋亡抑制因子及促血管新生因子为研究指标,观察临床不同时期的白血病患者血清硒、和的水平变化,并分析三者之闻的相关性,以进一步探讨体内硒抗肿瘤的作用机制及与细胞耐药的关方法留取例白血病患者血清标本,按病情进展阶段分为初发组、缓解组和难治/复发组。并取例正常人血清标本作为正常对照组。用原子荧光法定血清硒浓度,用酶联免疫吸附试验法同步测定血清和水平,其中水平以,后的较正值表示。并以直线相关比较白血病患者血清硒、和罅水平变化的相关性。结果硒浓度:白血病患者低于正常人。其中初发和难治,复发组较对照组有显著性差异尸.,.;难治/复发组降低尤为明显,较初发组亦有显著性差异.;缓解组与对照组之间差异无统计学意义.。水平;初发和难治,复发组明显高于对照组,差异有统计学意义.;难治,复发组亦显著高于初发组.;缓解组与对照组无显著性差异.。缸水平:初发和难治/复发组明显高于对照组和缓解组值均.,而缓解组与对照组之问无显著性差异.。例白血病患者血清硒浓度与血清水平及其与血清陆水平之间均成显著负相关关系分别为,..,.;..,.。
血清水平与血清风水平之间呈正相关关系.,.。以例白血病患者中位值/为界将首都医科大学硕士学位论文其分为两组:组/,结果发现,组和水平均明显低于组.,血硒浓度明显高于组.,差异均有统计学意义。结论难治/复发组血硒水平明显降低,和水平明显升高,提示硒、和与白血病细胞耐药有关,临床检测三者的水平可用于评价白血病的病情状态及转归。血清硒浓度与血清和的水平呈显著负相关关系,从临床角度提示白血病患者体内硒与细胞凋亡,血管新生有一定的相实验依据。关键词白血病,硒,,,多药耐药首都医科大学硕士学位论文硒是人体必需的微量元素之一,主要参与谷胱苷肽过氧化物酶等抗氧化酶的组成,具有抗氧化、维持人体多种正常生理功能的作用。近年来,人们逐渐发现硒具有抗肿瘤作用。上世纪年代,和首先发现美国不同地区的癌症死亡率与饮食中的硒含量有判。流行病学调查研究发现:摄入硒少【及血清硒含量低】【的人群癌症发病率高,二者成量的硒可以降低癌症的危险性和发病率。其中等人进行的肿瘤营养预防试验,是在西方国家进行的第一个验证补充硒可以减少肿瘤发生这一假说的随机双盲试验。此外,大量动物实验研究发现:硒能显著预防和抑制动物的自发性、移植性和化学致癌剂诱发的肿瘤的发生、发展、转移和复发,给动喂饲含硒化合物的饲料可以减少肿瘤的发生率】,等人发现合成的硒化合物能显著的抑制小鼠乳腺肿瘤的形成和生长。

同时对细胞系的研究亦表明:硒能诱导白血病细胞,骨肉瘤细胞【】,前列腺癌细胞【等的凋亡,抑制其生长。由此可见,临床干预实验,动物实验及体外研究均表明硒具有防癌抗癌作用,但其作用机制目前尚不十分清楚,通过大量的实验研究人们提出了以下些假说:、抑制癌细胞生物大分子合成和影响细胞周期:、影响致癌物质的代谢;、调节机体免疫功能;、抑制癌细胞增殖;、促进癌细胞凋亡;、抑制肿瘤血管生成【。其中硒抗肿瘤血管形成和诱导肿瘤细胞凋亡的机制是近年的研究热点。是血管内皮细胞生长因子,在血液系统恶性肿瘤中高水平表达。它不仅以旁分泌方式作用于血管内皮细胞促进血管新生,还以自分泌方式作用于瘤细胞本身,促进其生长,抑制其调亡,并可以增加白血病细胞对化疗药物的抵抗作用引起细胞耐药。等研究证明摄入预防剂量的富硒蒜、亚硒酸钠、硒半胱氨酸在某种程度上可以抑制肿瘤相关血管的形成和的表达,起到首都医科大学硕士学位论文化学预防作用【【。本实验组的前期研究亦表明:硒能抑制白血病细胞系受体的表达【,有逆转耐药的作用【。/是介导细胞调亡的一对重要膜蛋白分子。是缺乏跨膜区的分泌型分子,与有很高的亲和力却不引起调亡,间接起到抑制调亡的作用。

研究表明:白血病患者体内水平明显升高,提示白血病的发病与肿瘤细胞调亡障碍有关。硒在体外可以诱导白血病细胞系的凋亡,张哲文等研究表明:硒酸酯多糖可以通过依赖性.激活途径诱导白血病耐药细胞系/细胞的凋亡刎。关于硒抗肿瘤作用机制的研究目前多集中在动物实验和体外实验中,但由于硒代谢产物的一些特性是人体内所特有的,因此体外实验得出的结论是否用于人体尚无定论。关于肿瘤患者体内硒与凋亡抑制因子和促血管生成因子关系的研究尚未见报道。本文旨在研究白血病患者体内血硒浓度、血清和水平随不同病情进展阶段的变化,及硒与和的相关性,以初步探讨体内硒抗肿瘤的作用机制。首都医科大学硕士学位论文正文研究对象、材料与方法实验材料与仪器设备.主要试剂:..环己烷:广东汕头市西陇化工厂..钼酸钠:北京市化工厂..高氯酸:天津市鑫源化工厂..盐酸:北京市化工厂..氢溴酸:南召华鑫化工有限公司..氨水:广东汕头市西陇化工厂试剂盒:尚柏生物技术有限公司美国公司产品分.主要仪器设备:..荧光分光光度计:日本日立酶标仪:美国公司…低温冰箱:日本三洋..离心机:北京雷动尔.:美国研究对象.白血病组例血清标本来自于年月至年月在首都医科大学附属北京同仁医院血液科住院的白血病患者,均经临床表现,细胞形态学,流式细胞免首都医科大学硕士学位论文疫分型等确诊。
男例,女例,年龄.岁,中位年龄岁。其中初发纳入标准:经临床表现、细胞形态学、细胞组化染色、流式细胞免疫分型等实验室检查确诊的白血病患者,诊断及疗效标准见参考文献”。排除标准:合并肝肾功能异常、糖尿病、免疫系统疾病、严重活动性感染及其他恶性肿瘤性疾病的患者。.正常对照组例常规健康体检无异常发现的本院职工,男例,女例,年龄.岁,中位年龄岁。排除标准:合并肝肾功能异常、糖尿病、免疫系统疾病、严重活动性感染及其他恶性肿瘤者。 标本采集 取觋察对象清晨、空骏、不抗凝静脉血,小时内以转汾,分 钟离心,得血清标本,每份标本分装管,.冻存待测,避免反复冻融。 实验方法 .血硒测定:原子荧光法测定血清硒浓度 取样:称取.样品,加.混合酸液消化液放置过夜 消化:次日将样品逐渐加热,当激烈反应后溶液变无色,继续加热至 产生白烟,溶液逐渐变成淡黄色即达到终点。 调值:消化液冷却后加 混合液溶液成深粉红色, 用氨水及盐酸调至 …淡红橙色。 萃取:加?.%试剂,混匀,置沸水浴中煮分钟,取出立 首都医科大学硕士学位论文 即冷却,加?环己烷,振摇分钟,将全部溶液移入分液漏斗。待分层后 弃去水层,环己烷层转入带盖试管中。
测定:于激发光波长,发射光波长处测定荧光强度。 硒标准曲线绘制:准确吸取硒标准使用液、.、.、.及.加水 至,按样品测定步骤同时进行。硒含量在.以下时荧光强度与硒含量呈 线性关系,每次需做试剂空白与样品硒含量相近的标准管双份。 .血清水平测定:用双抗夹心酶联免疫吸附法测定血清 水平,操作步骤按说明书进行。为了平衡血小板数差异造成的系统误差,将每 份样本测定值/以其血小板计数.进行标化,最终以标化 值//作为研究指标。 .血清水平测定:用双抗夹心酶联免疫吸附法测定血清 水平,操作步骤按说明书进行。 统计学方法 数据以工表示,用方差分析进行组问比较。变量间的关系采用直线 相关系数的显著性检验。用 .软件包进行统计分析。 首都医科大学硕士学位论文 实验结果 血清硒、和在自血病的表达其中水平以/标 化值表示见表 .血硒浓度:三组白血病患者均低于正常人。初发和难治/复发组较对照组有 显著性差异.,.;难治/复发组降低尤为明显,较初发组亦有显著性 差异.:缓解组与对照组之间差异无统计学意义.。 水平:初发和难治/复发组明显高于对照组,差异有统计学意义.;难治/复发组亦显著高于初发组.;缓解组与对照组无显著性差 水平:初发和难治/复发组明显高于对照组和缓解组值均.,而缓解组与对照组之间无显著性差异.。
各组研究对象血清硒、/及水平的测定结果注:与正常对照组比较.,与初发组比较. 硒、和与之间的关系 例白血病患者的值经对数变换后,与硒、和之间无明显相 /,血清硒、和水平的比较,见表.结果显示:组/和值均明显低于组值均.,组硒浓度则明显高于 组.,差异均有统计学意义。 白血病、两组血清硒、/和之间的比较硒、及之间相关性测定 白血病组血清硒与水平的相关分析:示显著负相关关系,一.,.。见图 白血病组血清硒与水平的相关分析:示显著负相关关系.,.。见图 首都医科大学硕士学位论文 图白血病组血清硒与的相关关系散点图.白血病组血清与水平的相关分析:示显著正相关关.. .。见图 图白血病组血清与的相关关系散点图首都医科大学硕士学位论文 讨论 自血病的发生发展与白血病细胞增殖失控,分化障碍,凋亡受阻有关。以往 应用联合化疗治疗白血病主要通过抑制肿瘤细胞增殖来达到治疗目的,而细
